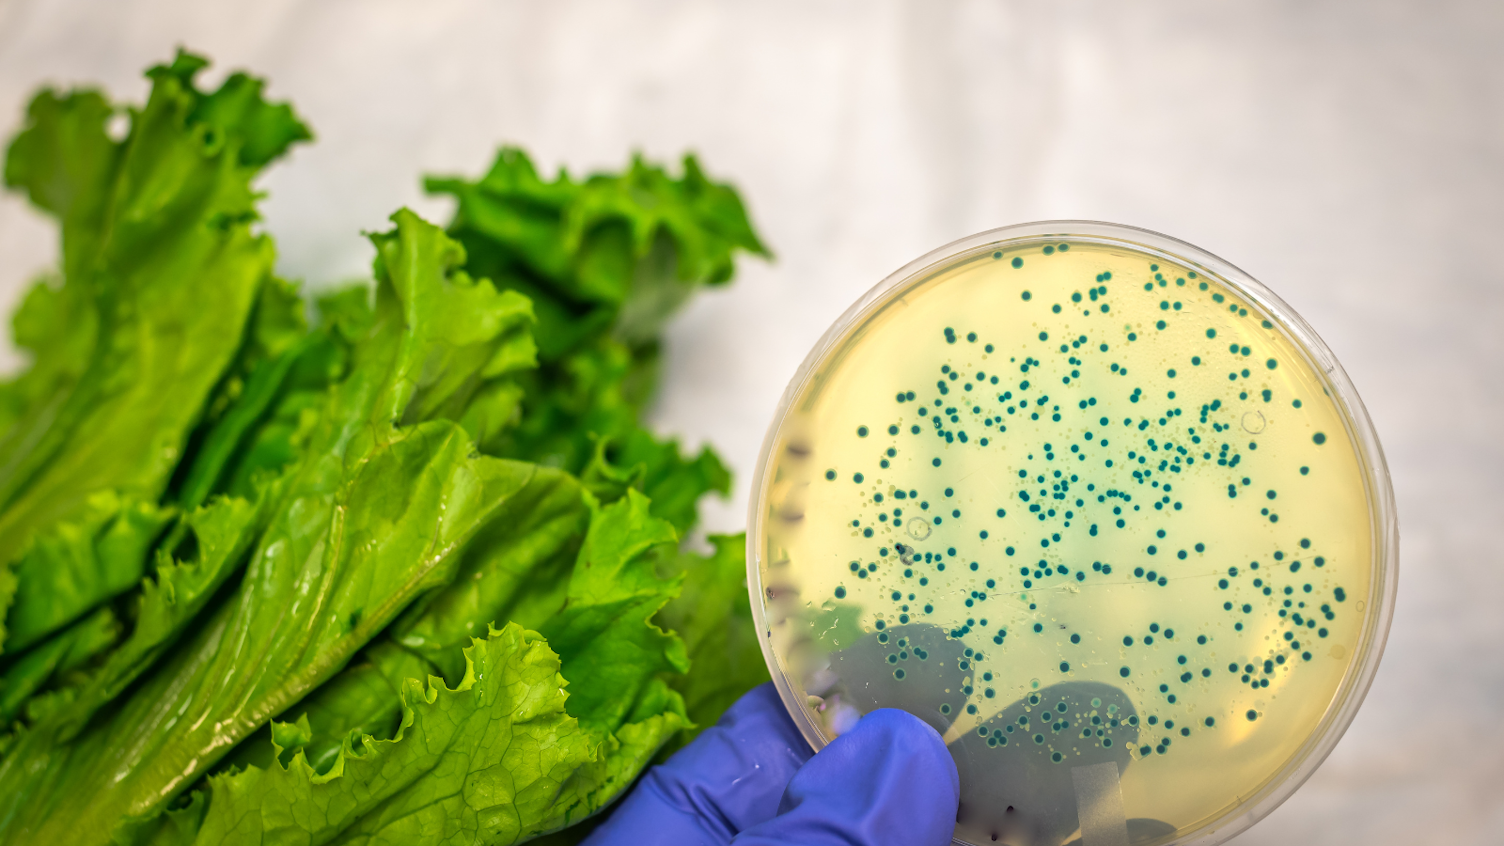
Zanieczyszczenia chemiczne w żywności mogą stwarzać zagrożenie dla zdrowia.

Skąd biorą się zanieczyszczenia chemiczne?
Zanieczyszczenia chemiczne spowodowane są głównie rosnącą chemizacją przemysłu rolno spożywczego, a także stosowaniem różnego rodzaju substancji chemicznych w wielu dziedzinach współczesnego życia. Mogą przenikać do żywności z:
- ziemi (przez nawozy),
- wody (ze ścieków i nawozów),
- powietrza (przez pyły i spaliny).
Mogą pojawiać się także w żywności, m.in., z powodu leczenia zwierząt antybiotykami, stosowaniu w hodowli substancji mających stymulować wzrost i rozwój zwierząt, czy przez opryskiwanie roślin środkami ochronnymi.
Co wchodzi w skład zanieczyszczeń chemicznych w żywności?
Do najczęściej występujących w żywności zanieczyszczeń chemicznych zaliczają się:
- konserwanty, barwniki, emulgatory, stabilizatory, itp.,
- nawozy mineralne (w tym azotany i azotyny),
- pozostałości pestycydów,
- substancje pochodzenia technologicznego (środki do dezynfekcji oraz mycia urządzeń i maszyn),
- metale ciężkie (kadm, ołów, arsen, miedź, rtęć, cynk),
Konserwanty, barwniki, emulgatory i stabilizatory są dodawane do żywności przez producentów na całym świecie, przede wszystkim w celu poprawy wyglądu żywności oraz przedłużenia jej terminu przydatności do spożycia. Warto jednak pamiętać, że nie zawsze są to substancje obojętne dla zdrowia, a nawet życia człowieka.
Nawozy mineralne są stosowane w celu wzbogacenia gleby w składniki mineralne, niezbędne do prawidłowego rozwoju roślin. Do tych substancji zaliczają się nawozy:
- azotowe,
- potasowe,
- fosforowe,
- wapniowe
Szczególnie niebezpieczne są nawozy azotowe, czyli azotany i azotyny, ponieważ wykazują właściwości rakotwórcze. Najwięcej azotanów kumulują takie warzywa, jak sałata, kapusta, rzodkiewki, buraki, kalarepa, szpinak oraz pietruszka.
Zanieczyszczenia chemiczne w żywności – kiedy są szkodliwe?
Stosowanie pestycydów w żywności jest szkodliwe, ich obecność w ludzkim organizmie powoduje zmiany mutagenne, teratogenne i nowotworowe. Pestycydy zaburzają gospodarkę hormonalną i enzymatyczną organizmu, są przyczyną chorób układu oddechowego, trawiennego, limfatycznego, jak również chorób skórnych.
Jeśli chodzi o metale ciężkie, to mogą być zanieczyszczeniem żywności lub naturalnym jej składnikiem. Ich zawartość w pożywieniu jest niewielka, stąd też nie wpływają istotnie na zaburzenie funkcji fizjologicznych organizmu. Jednak ich większa ilość może odkładać się w organizmie, prowadząc do nieodwracalnych zmian w ośrodkowym układzie nerwowym. Grupą szczególnie narażoną na działanie metali ciężkich są niemowlęta i małe dzieci.
Z koeli toksyny to substancje organiczne wytwarzane przez drobnoustroje, rośliny i zwierzęta. Wiele gatunków pleśni produkuje toksyny zwane mykotoksynami. Część z nich ma właściwości kancerogenne oraz mutagenne.
Przeciwdziałanie zanieczyszczeniom żywności
Obecnie najskuteczniejszym sposobem ochrony bezpieczeństwa i jakości żywności jest system HACCP (Hazard Analysis and Critical Control Points). Skuteczna eliminacja zagrożeń́ bezpieczeństwa żywności oraz ich systematyczna i efektywna kontrola pozwala na dostarczanie żywności o odpowiedniej jakości i bezpieczeństwie zdrowotnym.
Zapraszamy do kontaktu z Laboratorium Badań Żywności SGS Polska, które oferuje m.in. badania pozostałości leków weterynaryjnych, zawartości mykotoksyn czy testy na obecność pestycydów.
Sandra Ujma, ekspertka branży OGC w SGS Polska
Źródła:
-https://ncez.pzh.gov.pl/abc-zywienia/zanieczyszczenia-w-zywnosci-definicje-i-rodzaje-zanieczyszczen/
-https://haccp-polska.pl/badania-zywnosci-zanieczyszczenia
-http://www.mamz.pl/almanach/skrypty/4.sklchem/18.html
-https://1000dni.pl/0-6-miesiecy/zanieczyszczenia-w-zywnosci-czy-wiesz-czym-sa
-https://www.forummleczarskie.pl/raporty/1274,zanieczyszczenia-rodzaje-zanieczyszczen-i-sposoby-zapobiegania-im
-https://ncez.pzh.gov.pl/abc-zywienia/pozostalosci-pestycydow-w-zywnosci-jak-uniknac-narazenia-na-substancje-szkodliwe/



